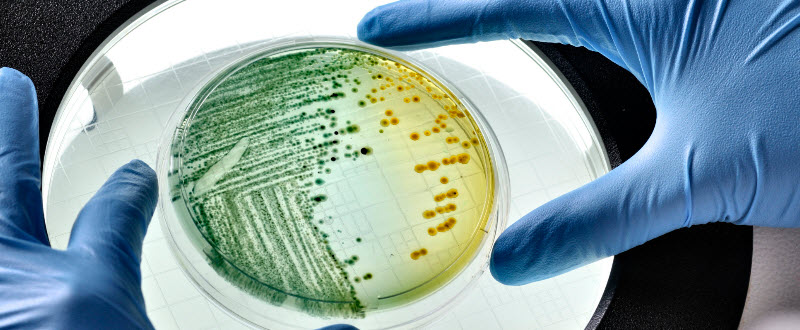

Del 18 al 24 de Mayo la Autoridad Europea de Seguridad Alimentaria (European Food Safety Authority, EFSA) celebró la Semana de la Seguridad Alimentaria. Compartimos con ustedes las notas más leidas sobre la inocuidad alimentaria.
Inocuidad Alimentaria: proteja su marca y a sus consumidores con LRQA: La industria alimentaria se enfrenta a clientes cada vez más exigentes, al endurecimiento de los requisitos del gobierno, problemas de marca, impacto ambiental, y problemas de crecimiento y rentabilidad.
Revolucionando el sistema no es una opción, sino un curso obligatorio en el mundo: ¿Por cuánto tiempo y cómo puede sostenerse el sistema agroalimentario del mundo?En la actualidad, la situación es alarmante: 800 millones de desnutridos y 1,6 millones de personas obesas; 40% del trigo producido en el mundo se convierte en combustible y forraje para animales; 1,2 millones de toneladas de alimentos simplemente se perdieron; la superficie cultivada del planeta se reducirá en un 20% a lo largo de unos treinta años, de acuerdo a las peores previsiones, debido a la desertificación.
¿Cuál es el mecanismo de resistencia de los herbicidas?: Investigadores de la Universidad de Adelaide han identificado el mecanismo detrás de la resistencia de la brome de malezas de cereales al herbicida glifosato utilizado. Los investigadores informan que se trata de las primeras especies de malezas en Australia que ha demostrado este mecanismo de resistencia.
Encirca ayuda a los cultivadores en tiempo real a mejorar la siembra: Real-Time Data Management Solutions ayuda a maximizar la productividad y rentabilidad. Más cultivadores aprovechan los servicios Encirca? de DuPont Pioneer para ayudarles a gestionar mejor los insumos y mitigar los riesgos, ya que siembran sus cultivos 2015.
La OPS y la OMS instan a reducir el consumo de azúcares en adultos y niños: Nuevas directrices de organismos recomiendan que adultos y niños reduzcan su ingesta diaria de azúcares libres a menos del 10% de calorías totales. También señalan que una reducción aún mayor, al menos del 5% –o aproximadamente seis cucharaditas por día en una dieta de 2.000 calorías–, proporcionaría beneficios adicionales para la salud.
Un tercio de la población del Reino Unido podría contraer una intoxicación alimentaria: Hoy se conmemora el inicio de la Semana de Seguridad Alimentaria 2015 y una vez más el centro de atención está en Campylobacter. La Food Standards Agency (FSA) dio a conocer nuevas cifras que sugieren que hasta un tercio de la población del Reino Unido podría contraer una intoxicación alimentaria de Campylobacter durante su vida.
Nuevos descubrimientos para reducir la floración de grasa en el Chocolate: Un estudio de rayos X realizado en DESY (Deutsches Elektronen-Synchrotron) permite mejorar la calidad del chocolate. El estudio ofrece nuevos conocimientos sobre la formación de la floración de grasa, una capa blanca desagradable que se forma de vez en cuando en el chocolate.
Campos eléctricos pulsados de bajo consumo para conservar la leche: Las respuestas pueden encontrarse en la investigación de la Universidad de Tel Aviv nueva publicada en Tecnología, que considera que los campos eléctricos pulsados ??cortos se pueden utilizar para matar las bacterias de la leche contaminante.
DuPont convoca a expertos en Innovación para garantizar la Seguridad Alimentaria Mundial: Dentro de los actos asociados a su participación en Expo Milán 2015, la compañía invita a líderes mundiales a debatir sobre este tópico, en una sesión en la que también se presenta la actualización del Índice Global de Seguridad Alimentaria.
Cuatro millones de niños latinoamericanos padecen de obesidad:Los niños pasan muchas horas dentro de espacios cerrados, realizando actividades sedentarias como ver televisión, jugar con videojuegos o con la computadora.
Un yogurt con mayores cepas probióticas ayuda a mejorar el organismo:Se sabe que el yogurt cumple un rol importante en la alimentación, ya que contiene bacterias beneficiosas que contribuyen al correcto cuidado del organismo.
Nuevos conocimientos sobre las esporas de Clostridium podrían interrumpir la germinación de la bacteria: Clostridium botulinum son bacterias que producen la toxina letal ya conocida. Incluso pequeñas cantidades de esta toxina en la derivación de alimentos es mortal en el 10% de los casos.
CytoGuard-YM : Inhibidor de moho natural de alta potencia: A & B Ingredientes dio a conocer la última incorporación a su línea CytoGuard de antimicrobianos y la vida útil. El inhibidor de moho natural de alta potencia, CytoGuard-YM está diseñado para ayudar a proteger una amplia gama de productos alimenticios desde el crecimiento de moho y la rancidez.
Creación de alianzas en torno a los bioplásticos :Holland bioplastics tiene como objetivo difundir, compartir y acceder a los conocimientos y la creación de alianzas en torno a los bioplásticos.
La creciente conciencia sobre el agotamiento de recursos y el cambio climático, sería menos dependiente de los países productores de petróleo y el deseo de crear una economía más basada en bio, si used se asegura de brindar más atención en los bioplásticos.
Soluciones de embalaje activo para controlar las condiciones atmosféricas: La humedad y el oxígeno pueden afectar a la estabilidad química o física de productos farmacéuticos, nutracéuticos y productos de diagnóstico. Los nutracéuticos están causando un acalorado debate porque su concepto redefine las líneas divisorias tradicionales entre los alimentos y los medicamentos.
¿Que son los AEROBIOS MESOFILOS?: Son todas aquellas bacterias aerobias o anaerobias facultativas, mesófilas o psicrófilas capaces de crecer en agar nutritivo. Se investigan por el método de recuento en placa con siembra en profundidad, ...
Fitomejorador crea soja fértil resistente a la roya y otros patógenos: Tuvieron que pasar décadas de arduo trabajo, pero el genetista Ram Singh logró cruzar unas variedades de sojas populares ("Dwight" Glycine max ) con una planta perenne silvestre relacionada como una mala hierba en Australia, ha logrado la primera producción de plantas de soja fértiles resistentes a roya de la soja, al quiste nematodo y otros patógenos.
Food Revolution Day: La revolución en la alimentación empieza por la educación a los más pequeños :La revolución en la alimentación consiste en cambiar el mundo de la comida tal como lo conocemos. Por esto, el próximo 15 de mayo el chef británico, Jaime Oliver, impulsa el Food Revolution Day para prevenir la obesidad. #FoodRevolutionDay